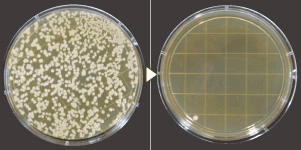

目には見えなくても、私たちが暮らす日常空間には様々な細菌が潜んでいます。 その対策として有効な手段が、塩と水を電気分解して生成する「電解水」。 洗浄力の「アルカリ性電解水」と除菌力の「酸性電解水」が、施設の衛生管理をサポートします。 しかも、生成には薬品類をいっさい使用しないため、安心してご使用いただけます。 食品業界や福祉施設をはじめ幅広いシーンで、清潔な環境作りをお手伝いいたします。
細菌への有効な手段「電解水」。
洗浄力の「アルカリ性電解水」。 除菌力の「酸性電解水」。電解水の二つのチカラが、細菌を除去した真の「清潔」を実現します。
電解水の生成に必要なのは「水」と「塩」と「電気」だけ
 電解水の生成に特別な原料は必要ありません。必要なのは「水」と「塩」と「電気」だけ。 水道水に含まれているカルキや有機塩素化合物、チリ、ゴミ等を軟水器とフィルターを通して徹底的に除去。 この水と塩水を電気分解することにより、「アルカリ性電解水」と「酸性電解水」が生成されます。マイナス(-)の電極側から洗浄力の高いpH約12.0のアルカリ性電解水と、プラス(+)の電極側から除菌力の高いpH約3.0(有効塩素濃度20~60mg/kg)の酸性電解水が生成されます。
電解水の生成に特別な原料は必要ありません。必要なのは「水」と「塩」と「電気」だけ。 水道水に含まれているカルキや有機塩素化合物、チリ、ゴミ等を軟水器とフィルターを通して徹底的に除去。 この水と塩水を電気分解することにより、「アルカリ性電解水」と「酸性電解水」が生成されます。マイナス(-)の電極側から洗浄力の高いpH約12.0のアルカリ性電解水と、プラス(+)の電極側から除菌力の高いpH約3.0(有効塩素濃度20~60mg/kg)の酸性電解水が生成されます。

電解水を洗濯水として使用した際の除菌効果
| オムツカバー | |
|---|---|
| 除菌前 | 除菌後 |
 |
|
| 下着 | |
|---|---|
| 除菌前 | 除菌後 |
|
|





